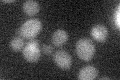
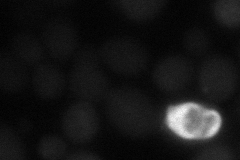
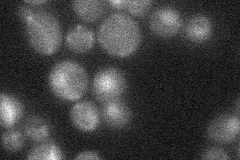
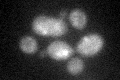

View description
Haploid-specific gene repressed by a1-alpha2, turned off in sir3 null strains, absence enhances the sensitivity of rad52-327 cells to campothecin almost 100-fold
Localization:
Intensity:
Fold change:
Significance:
-
C’ GFP library in SD
below threshold14.94 -
N' NOP1pr-GFP in SD

below threshold24.3108 -
N' TEF2pr-mCherry in SD
below threshold29.919 -
N' NATIVEpr-GFP in SD
below threshold20.8751 -
N' TEF2pr-VC and Cyto-VN in SD

below threshold20.6927 -
C’ GFP library in SD+DTT
cytosol17.041.14No -
C’ GFP library in SD+H2O2

cytosol16.431.09No -
C’ GFP library in Starvation Media

cytosol21.941.46No -
C’ GFP library on the background of Pup2-DaMP

N/A -
C’ GFP library on the background of CCT mutant

N/A0N/AYes
